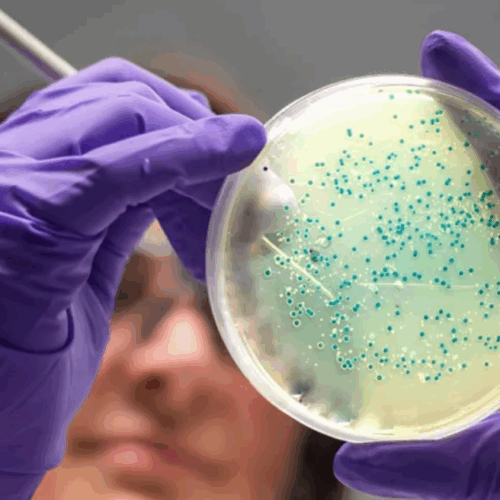

काठमाडौं । आर्टिफिसियल इन्टेलिजेन्स (एआई) ले गोनोरिया र एमआरएसए जस्ता औषधि–प्रतिरोधी संक्रमणलाई मार्न सक्ने दुई नयाँ सम्भावित एन्टिबायोटिक विकास गरेको अनुसन्धानकर्ताहरूले खुलासा गरेका छन् । एआईले यी औषधिलाई परमाणु–स्तरमै डिजाइन गरेको हो, जसले प्रयोगशाला र जनावरमा गरिएका परीक्षणमा सुपरबग्सलाई नष्ट गर्यो ।
तर यी दुवै यौगिक अझै परिमार्जन र क्लिनिकल परीक्षणका लागि केही वर्ष लाग्नेछ, त्यसपछि मात्र चिकित्सकहरूले यसको प्रयोग गर्न सक्नेछन् । तर यस अनुसन्धानको पछाडि रहेको म्यासाचुसेट्स इन्स्टिच्युट अफ टेक्नोलोजी MIT) टोलीले भनेको छ कि एआईले एन्टिबायोटिक खोजमा “दोस्रो सुनौलो युग“ सुरु गरिदिन सक्छ । एन्टिबायोटिकहरूले ब्याक्टेरियालाई मार्छन्, तर उपचारमा प्रतिरोध गर्ने संक्रमणका कारण हरेक वर्ष करिब एक मिलियनभन्दा बढी मानिसको ज्यान जाँदैछ ।
पहिले, अनुसन्धानकर्ताहरूले हजारौँ ज्ञात रसायनहरूबीच एआई प्रयोग गरी सम्भावित नयाँ एन्टिबायोटिक खोज्ने प्रयास गरेका थिए ।तर यसपटक एमआईटीको टोलीले एक कदम अगाडि बढ्दै, गोनोरिया (यौनजन्य रोग) र सम्भावित घातक एमआरएसएका लागि सीधै जेनेरेटिभ एआई प्रयोग गरेर नयाँ एन्टिबायोटिक डिजाइन गरेको हो ।
जर्नल सेलमा प्रकाशित अध्ययनअनुसार, एआईले ३ करोड ६० लाख यौगिकको विश्लेषण गर्यो, जसमा केही अझैसम्म अस्तित्वमै छैनन् वा खोजिएका छैनन् । वैज्ञानिकहरूले एआईलाई विभिन्न रसायनिक संरचना र तिनले ब्याक्टेरियाको वृद्धिलाई कसरी रोक्छन् भन्ने डेटा दिएर तालिम दिएका थिए ।
एआईले त्यसपछि कार्बन, अक्सिजन, हाइड्रोजन र नाइट्रोजन जस्ता परमाणुबाट बनेका अणुसंरचनाले ब्याक्टेरियालाई कसरी असर गर्छ भन्ने बुझ्न सिक्यो । वैज्ञानिकहरु अझै क्लिनिकल परीक्षणका लागि तयार छैनन् । यी औषधिलाई थप परिमार्जन गर्न कम्तीमा एक–दुई वर्ष लाग्ने अनुमान छ ।
फ्लेमिङ इनिसिएटिभ र इम्पेरियल कलेज लण्डनका डा. एन्ड्रु एडवड्र्सले यसलाई ‘अत्यन्तै महत्त्वपूर्ण र विशाल सम्भावना भएको काम’ भनेका छन्। तर उनले थपे, “एआईले औषधि खोजलाई सुधार्ने वाचा गरेको छ, तर सुरक्षा र प्रभावकारिताका परीक्षणमा अझै कठिन काम गर्नैपर्छ।’ यो प्रक्रिया लामो र खर्चिलो हुने सम्भावना छ, र अन्ततः औषधि प्रयोगमा आउने वा नआउने निश्चित छैन ।

प्रतिक्रिया